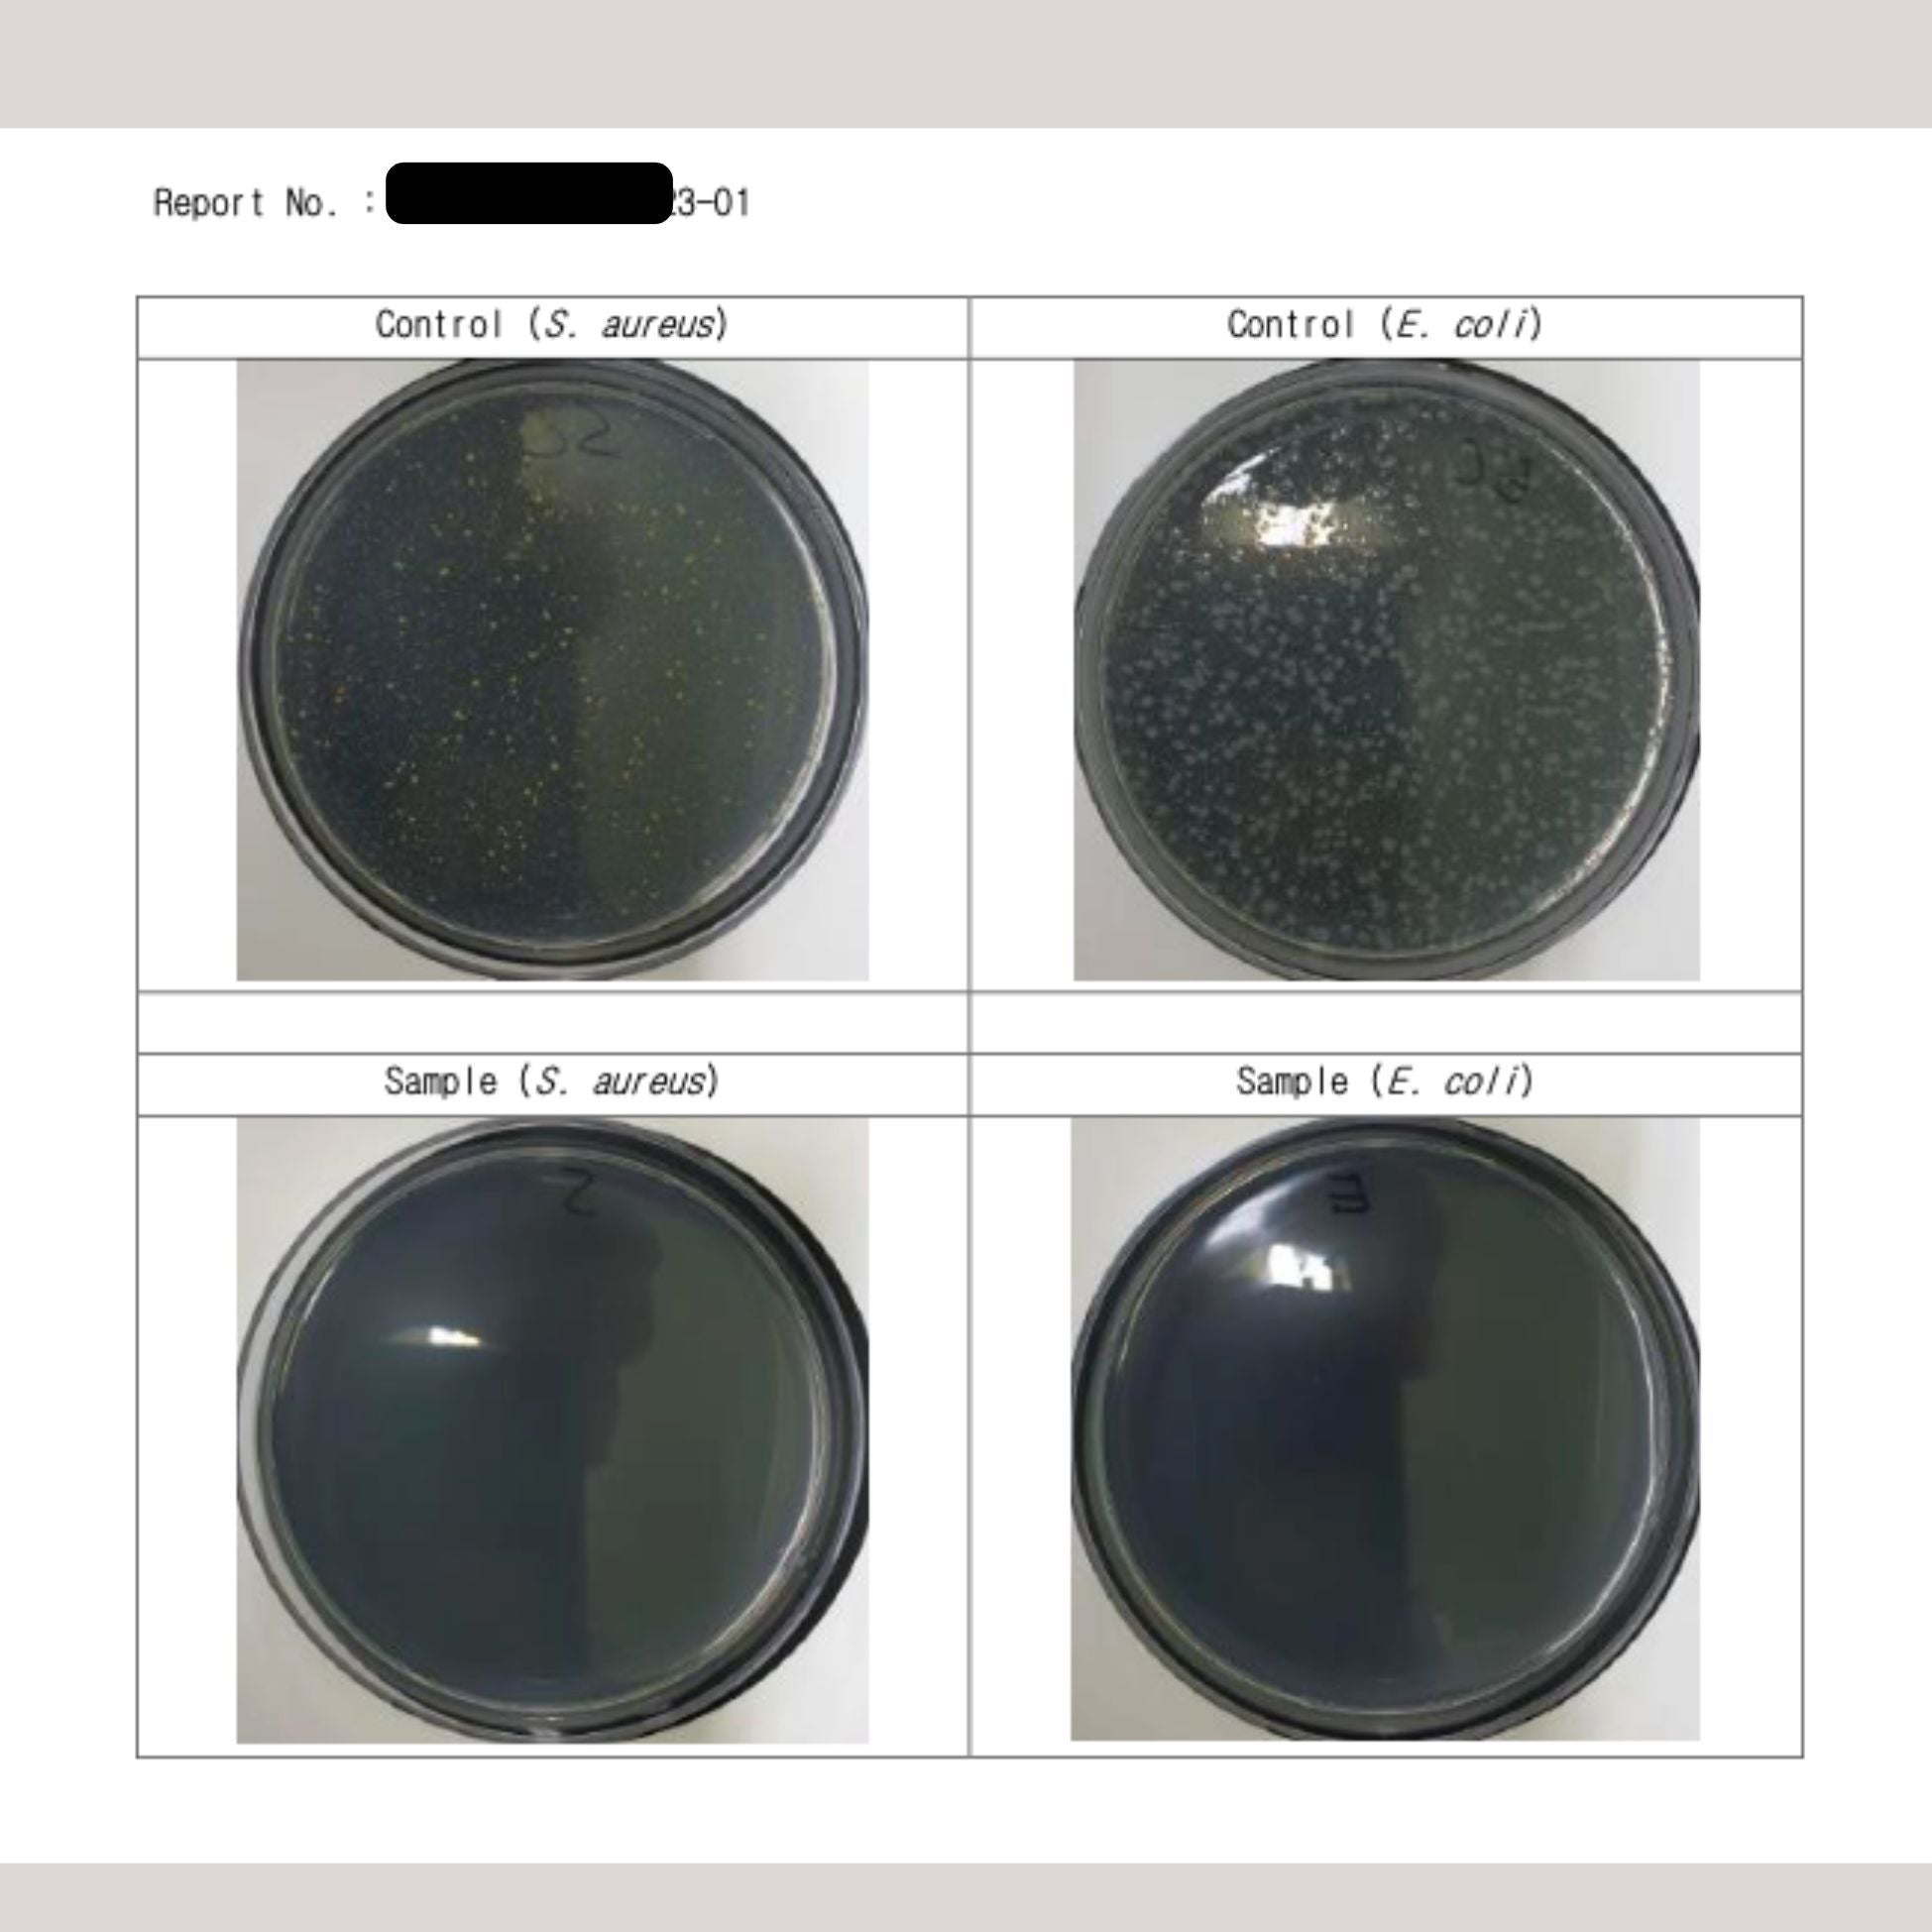
Wasabi Skin Sanitiser 30ml

Wasabi Skin Sanitiser 30ml
- Regular price
-
$12.80 - Regular price
-
- Sale price
-
$12.80
Our natural skin sanitiser is based on wasabi extract! It is an effective anti bacterial and anti-viral active ingredient.
Lab tested and effective against
- Staph. A (Staphylococcus aureus) Bacteria
- E. Coli Bacteria
- A. Niger Bacteria
- Influenza A Virus ( Same family as H1N1)
With added Broccoli extract that is effective against
- H. Plyori bacteria
Wasabi extract used in this product is equivalent to 65% ethanol in killing of the above bacteria strains. See this video on efficacy against germs and bacteria or see our gallery image for lab testing for Staph. Aureus and E.Coli bacteria.
Especially crucial for eczema skin management
If you have dry flaky eczema skin, your skin barrier is broken and this means bacteria and germs is going to attack your skin.
For eczema skin especially if it is dry, flaking and with skin fissures, sanitise with our wasabi sanitiser after showering. Let sanitiser absorb unto skin and apply an oil moisturiser. See this video on how to manage eczema skin.
Contains hyaluronic acid for increased moisture comfort.
And don't worry! Its will not sting! It is an extract.
Good for skin warts, pus/infected pimples or any skin areas that require sanitisation.
Avoid eye areas.
Alcohol Free.
500ml refiils available.
Lab tested and manufactured in Korea.
in 30ml plastic bottle
Full Ingredient List
Water, Lactobacillus/Wasabia Japonica Root Ferment Extract, Brassica Oleracea Italia ( Broccoli) Extract, Propandiol (from corn),glycerin, Scutellaria Baicalensis root extract,Lactobacillus Ferment, glycerin, Glcyrrhiza Uralensis( Licorice) Root extract, Camelia Siensis Leaf water, Cocos Nucifera ( coconut oil), Allium Sativum ( Garlic Bulb Extract), Yeast Ferment Extract, Sodium Hyaluronate, Polyglyceryl-10 Laurate (from coconut) Melaleuca Alternifolia ( Tea Tree ) Leaf Oil.
Tea tree essential oil is at 0.3%. For scent purpose only.
Skincare Step
Mist over affected area. Let it absorb. Or mist onto hands and dab onto affected spots.
Best Before
Best Before 07/2027
Couldn't load pickup availability

Wasabi Skin Sanitiser 30ml
- Regular price
-
$12.80 - Regular price
-
- Sale price
-
$12.80
FAQs
Wasabi Skin Sanitiser 30ml
Does it sting? No. It is an extract. It feels like a normal sanitiser with a faint tea tree scent.